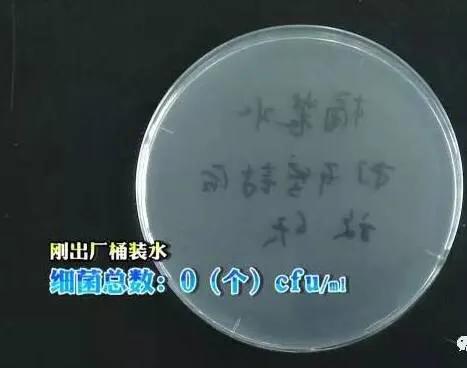
纯净水细菌总数标准,纯净水细菌含量高吗
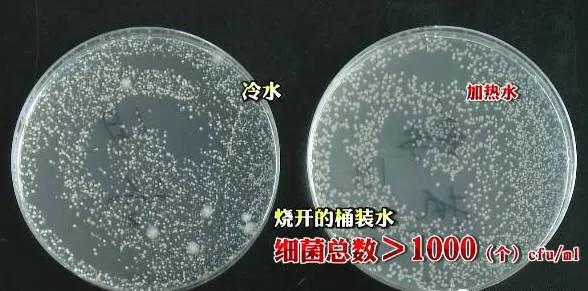
纯净水细菌总数标准,纯净水细菌含量高吗

想必大家每天喝的是大桶水或自来水吧!
但是,网上有传言说:饮水机里的桶装水在开封6天后,细菌总量会严重超标,还不如喝自来水来的卫生!
不管你信不信,反正对一个常年喝桶装水,年年体检都是三高的码字*党**来说,我是不信的!
口说无凭,实验为证!
其实我不理解,为啥老拿自来水当炮灰,“细菌严重超标,还不如喝自来水”!
取普通的自来水,取样后经过24小时培养,发现自来水样本中的细菌含量是1个/ml。
而国标对生活饮用水的细菌规定是:每100ml饮用水中细菌总数不得超过100个!
看看,就细菌数而言,自来水还是很干净的!
为了检测桶装水的细菌含量,挑选了一款出厂才5天的桶装水,对它出水口消毒后采集了样本。

经过检测发现,这桶水的细菌为0个/ml
这么干净的水,装上饮水机难道真的就会细菌超标吗?
找来两台饮水机,一个是全新的,一个是用了三年,半年前才清洗过的旧饮水机。
为了保证实验结果准确,先用烧开的沸水冲洗和浸泡饮水机内管三遍。

然后用75%的酒精对饮水机内腔以及出水口消毒。

最后放上桶装水后,分别从冷水口和热水口放出500ml水冲洗饮水机内部管路。

清洗完毕后取样检测,发现两款饮水机的细菌总数都是0个/ml,说明两台饮水机里的水目前都没有被污染。

把桶装水放在饮水机上静置6天后,再取样检测,结果发现这两桶水中的细菌总数都大于1000个/ml。

这密密麻麻的,看的鸡皮疙瘩都起来了!
而《生活饮用水标准》GB5749-85规定:每100ml饮用水中的细菌总数不得超过100个。显然,在饮水机上放了6天的桶装水,已经完全达不到国家生活饮用水标准了!
那么问题来了:细菌到底是哪儿来的呢???
浙江省人民医院检测中心主管技师说:空气中的细菌只有吸附到某个平台后才会繁殖,而桶装水与饮水机的交界面,由于空气湿润,刚好给细菌的繁殖提供了理想的环境。也就是说,饮水机本身就是一个细菌的大!温!床!

为了验证这个观点,我们打开了一桶新的水,这次没有放上饮水机,只是在桶口放上了一个一次性杯子。

同样静置6天后,检测发现桶装水里的细菌含量依然是0个/ml,也就是说,加了盖的桶装水由于几乎没有和外界接触,细菌无法进入,所以细菌数量没有增加。

可能有人会说,你们测的都是冷水,我喝的都是饮水机里烧开的热水,热水里的细菌总没有这么多了吧?
还是用在饮水机上静置6天后的水,烧开后取样检测,结果显示:和冷水相比,烧开的热水中的细菌总量并没有明显减少,只是细菌的种类明显减少。
这又是为什么呢?
原因很简单,因为饮水机只能加热到七八十度,并不能完全煮沸,而这个温度对大部分细菌很难起到杀灭的作用!

实验到这儿,我们基本可以得出结论:饮水机就是导致桶装水细菌超标的罪魁祸首!

翼猫科技智能净水系统,
还原水的纯净,为你的饮水安全保驾护航!

RO反渗透技术
翼猫智能净水系统,采用世界上制造净水的核心“RO反渗透技术”,能有效去除水中的溶解盐、胶体、细菌、病毒、细菌内毒素和大部分有机物等杂质,除盐率一般为98%以上。
实时在线监测水质
翼猫科技首款产品智能净水系统采用自主知识产权的远程物联网监控技术,每6秒检测一次水质安全,一旦监测到水质出现问题,系统会发出警报并立即切断水源,服务人员第一时间主动预约,上门免费解决问题。
四个实时
实时监测、实时检测、实时上传、实时处理
五个免费
免费赠机、免费安装、免费维护、免费更换滤芯、免费更新换代。